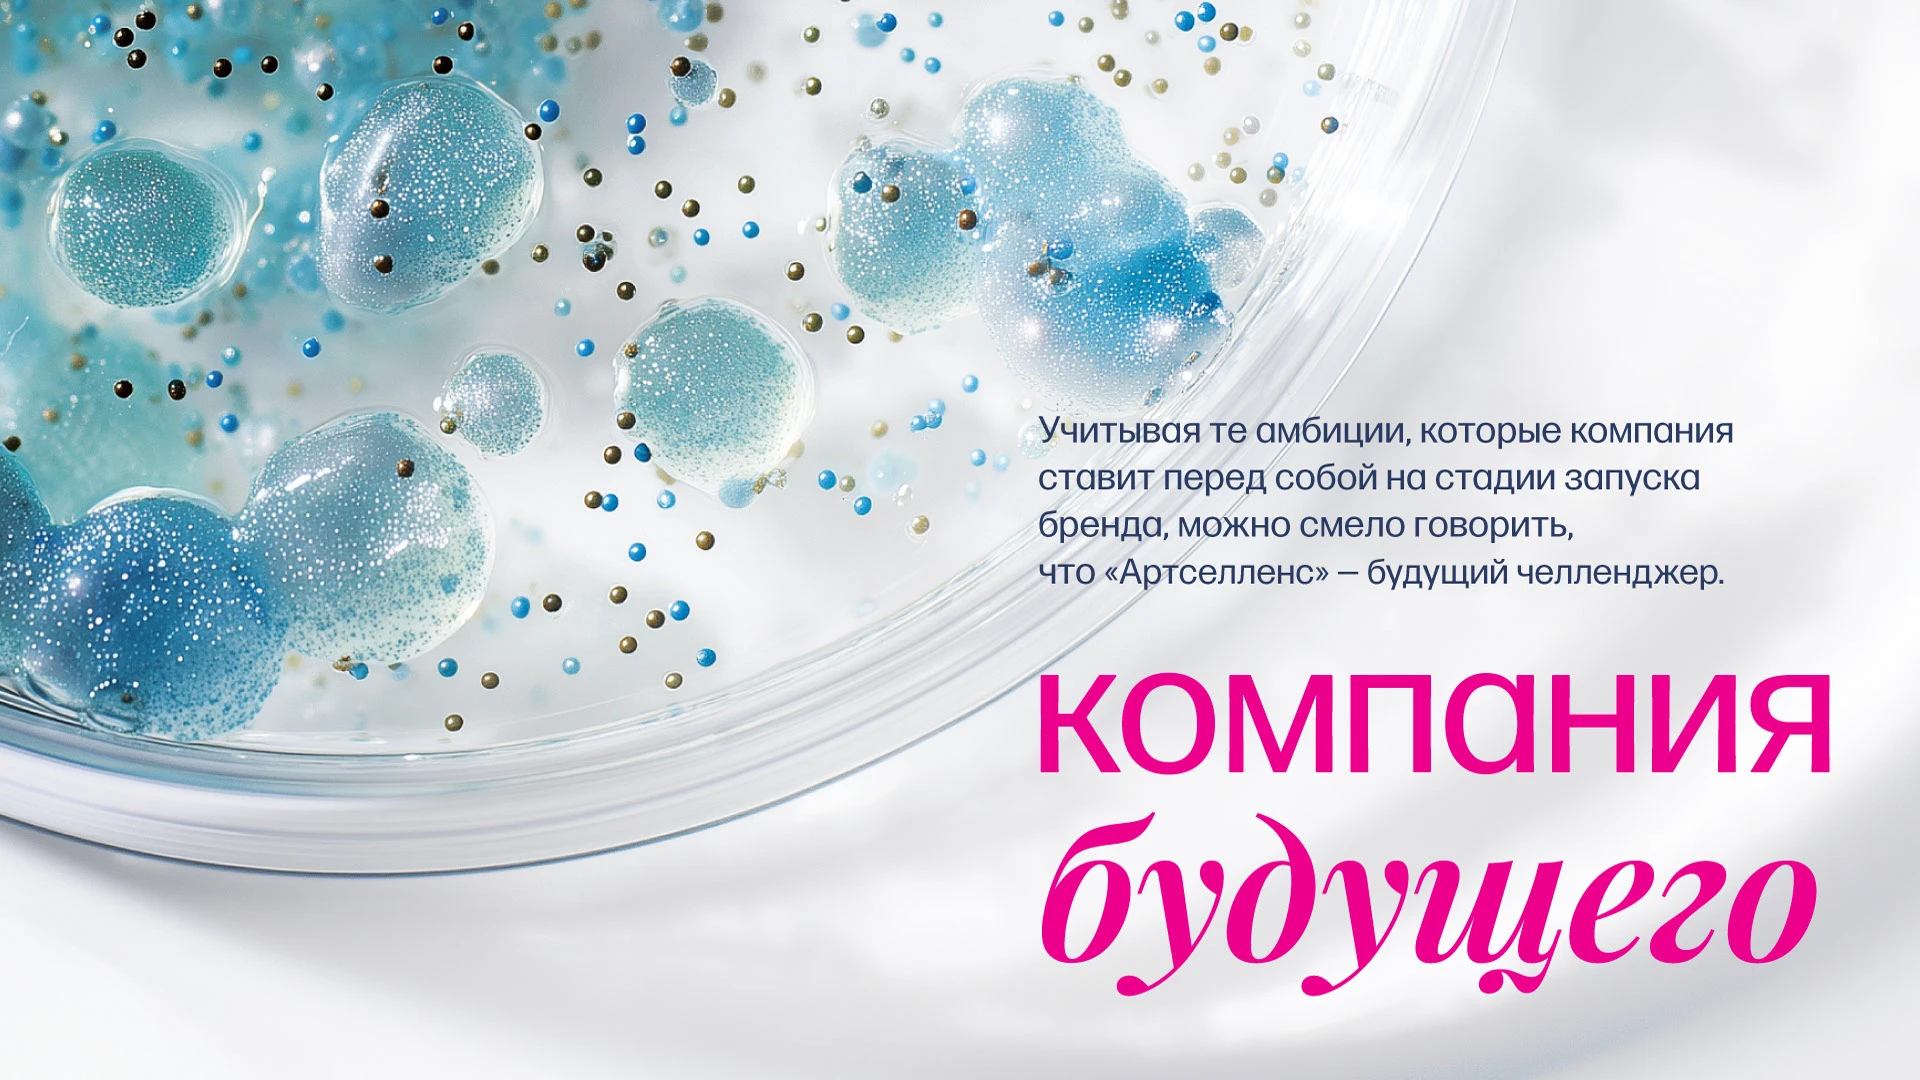
Приручать неизвестность. Брендинг «Артселленс» — Изображение №4 — Брендинг, Графика на Dprofile

Приручать неизвестность. Брендинг «Артселленс»
Клиент:
биотехнологическая компания «Артселленс»
Задача:
разработать платформу бренда, фирменный стиль и брендбук
Биотехнологическая компания «Артселленс» основана ведущей инновационной биотехнологической группой компаний «Промомед». Основным направлением деятельности «Артселленс» является полный цикл производства биоаналогов и инновационных биотехнологических препаратов для лечения онкологических, аутоиммунных и других социально значимых заболеваний.
нагнетая конкуренцию
«Артселленс» стремится стать современным научным биотехнологическим хабом — лидером отрасли, разрабатывать прорывные продукты и задавать новые стандарты рынка. Поэтому руководство компании обратилось к нам за разработкой фирменного стиля и платформы бренда, которые бы отражали ее стремления и амбиции.
быть на шаг впереди
По итогам стратегической сессии, анализа конкурентов, их коммуникации, а также с учетом тех амбициозных целей, которые компания ставит перед собой на стадии запуска, мы сформировали новое позиционирование для «Артселленс» с точки зрения бренда-челленджера и компании будущего, решения которой всегда на шаг впереди проблемы или болезни.
Сутью бренда стала фраза — «приручать неизвестность». Она в полной мере отражает энергичный и целеустремленный характер «Артселленс», желание его сотрудников ощущать азарт от возможности драйвить фармацевтический рынок, выходить за рамки возможностей и каждый день создавать прорывные, но доступные и проверенные продукты.
видеть глубже, идти дальше
В своей работе мы стремились избегать избитых образов и клишированных решений, таких как изображения клеточных оболочек или цепочек ДНК, и взяли за основу куда более специализированный научный образ — РНК‑транскрипт.
Если говорить простым языком РНК‑транскрипт — это новая молекула РНК, которая создается на основе ДНК в процессе транскрипции, при котором генетическая информация переписывается с ДНК на РНК. При этом перенос этой информации идет строго в одном направлении: от конца молекулы, обозначаемого цифрой 5’, к концу, обозначаемому 3’.
пространство возможностей
Для нас же 5’ и 3’ — стали не только главными элементами коммуникации, а настоящей квинтэссенцией бренда «Артселленс». Они отсылают и к структуре РНК‑транскрипта, и символизируют границы пространства возможностей: место, где рождаются новые технологии, формируются прорывные идеи и создаются решения для наиболее сложных биотехнологических задач.
В 5’ и 3’ словно в кавычки заключаются мотивирующие слоганы, акцентные цитаты, важные информационные блоки и даже само название компании, что усиливает узнаваемость и подчеркивает научную основу бренда. В них же размещаются различные графические элементы — иконки, схемы, фотографии и фрагменты иллюстраций. Что создает ощущение живого процесса поиска и экспериментов.
Такой подход дает нам максимальную свободу решений и гибкость в коммуникации. Заполняя пространство между 5’ и 3’ разным контентом, мы можем легко менять содержание сообщений в зависимости от контекста и аудитории. Коммуникация может быть как более серьезной и наукоемкой, так и наоборот более азартной и вдохновляющей, сохраняя при этом абсолютную узнаваемость.
на стыке трех цветов
Помимо необычных графических решений бренд «Артселленс» выделяет яркое и новаторское для сферы сочетание цветов: акцентной чистой мадженты, бирюзового и базового темно-синего. Таким образом, мы подчеркиваем специализацию компании, но за счет смелого акцента даем понять, что мы — другие: более активные, динамичные, адаптивные, горящие своим делом.
лаборатория графики и форм
Для того чтобы сохранить консистентность фирменного стиля и облегчить клиенту дальнейшую с ним работу, мы разработали обширную дизайн-систему графических элементов, которые так или иначе передают процесс поиска, создания и трансформации идей и решений.
результат
В итоге у нас получилась целостная платформа бренда, которая перевела амбиции «Артселленс» на язык конкретных смыслов и стала фундаментом для всех дальнейших коммуникаций, а также минималистичный, емкий, яркий и максимально пластичный фирменный стиль, с которым легко и интересно работать. Он сочетает в себе научный бэкграунд со специфическими фишками, что поймет только профессионал, и открытую коммуникацию с людьми общего профиля. Но главное — это демонстрация сути и характера компании, которая находится в постоянном эксперименте, чтобы решать глобальные задачи.
Как рассказал нам клиент, проделанная работа стала основой для мощного старта бренда. «Артселленс» уже запустил технологическую линию по производству инновационных лекарственных биопрепаратов в первых производственных корпусах, а команда в лабораториях вовсю драйвит рынок, приручает неизвестность и создает будущее.
РАБОЧАЯ ГРУППА
арт-директор
Ирина Шмидт
бренд-стратег
Мария Ануфриева
копирайтер
Сергей Воробьев
дизайнер
Иван Толк, Аделина Артюшкина
менеджер проекта
Марина Андреева
над кейсом работали
Аделина Артюшкина, Сергей Воробьев
сайт | telegram